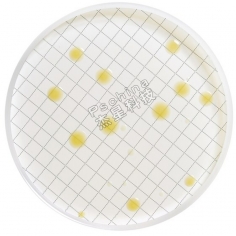

间充质干细胞的扩增
间充质干细胞的扩增
一旦细胞达到约80%的汇合并且正在积极增殖时,传代培养细胞。
重要提示:在达到100%汇合之前进行传代细胞培养。小心地从含有人间充质干细胞汇合层的10 cm组织培养板中取出培养基。涂抹3-5 mL胰蛋白酶-EDTA溶液 (SM-2003-C),并在37℃培养箱中孵育3-5分钟。
用手掌轻轻拍板的侧面,检查板上的细胞完全脱离。
向板中加入5 mL间充质干细胞扩增培养基 (SCM015 or SCM045)。
轻轻旋转培养板以混合细胞悬液。将解离后的细胞转移到15 mL锥形管中。
将试管以300 × g离心3-5分钟以沉淀细胞。
丢弃上清液。
将含有8 ng/mL FGF-2的2 mL间充质干细胞扩增培养基(预热至37°C)加于锥形管,并彻底重悬细胞。
重要提示:请勿涡旋细胞。使用血细胞计数器计数细胞。
将细胞以5,000-6,000个细胞/cm2的密度接种到含有8 ng/mL FGF-2的间充质干细胞扩增培养基的适当培养瓶、板或孔中。
细胞可以2 × 106个细胞/小管的密度混入MSC生长培养基及10% DMSO(D2650)中冷冻。
电话:400-800-5586



 膜康MOCON
膜康MOCON  默克Merck
默克Merck  日立HITACHI
日立HITACHI  艾科琳Airclean
艾科琳Airclean  赛默飞ThermoFisher
赛默飞ThermoFisher  毕恩思BIENSI
毕恩思BIENSI  古莎KULZER
古莎KULZER  LAMPLAN
LAMPLAN  迈格MEGA
迈格MEGA  奥德镁QATM
奥德镁QATM  徕卡Leica
徕卡Leica  威尔逊Wilson
威尔逊Wilson  基恩士KEYENCE
基恩士KEYENCE  普兰德Brand
普兰德Brand  CEM
CEM  维根斯WIGGENS
维根斯WIGGENS  森信SENXIN
森信SENXIN  蔡司Zeiss
蔡司Zeiss  美国CEM
美国CEM  和泰HHitech
和泰HHitech  日本ATAGO
日本ATAGO  杭州彩谱
杭州彩谱  日本KEM
日本KEM  上海尧勋
上海尧勋  浩谱嘉
浩谱嘉  安捷伦Agilent
安捷伦Agilent  布拉本德Brabender
布拉本德Brabender  上海屹尧
上海屹尧  奥豪斯OHAUS
奥豪斯OHAUS  宾德BINDER
宾德BINDER  博勒飞Brookfield
博勒飞Brookfield  博迅Boxun
博迅Boxun  苏伊士suez
苏伊士suez  安东帕
安东帕 


 亚速旺AS ONE
亚速旺AS ONE 


 埃德伯格
埃德伯格  BIOBASE
BIOBASE  众御ZOYET
众御ZOYET  乐普乐吉Looped Logic
乐普乐吉Looped Logic  博科
博科 


 弗霓FU
弗霓FU  梅特勒Mettler Toledo
梅特勒Mettler Toledo  汉钠HANNA
汉钠HANNA